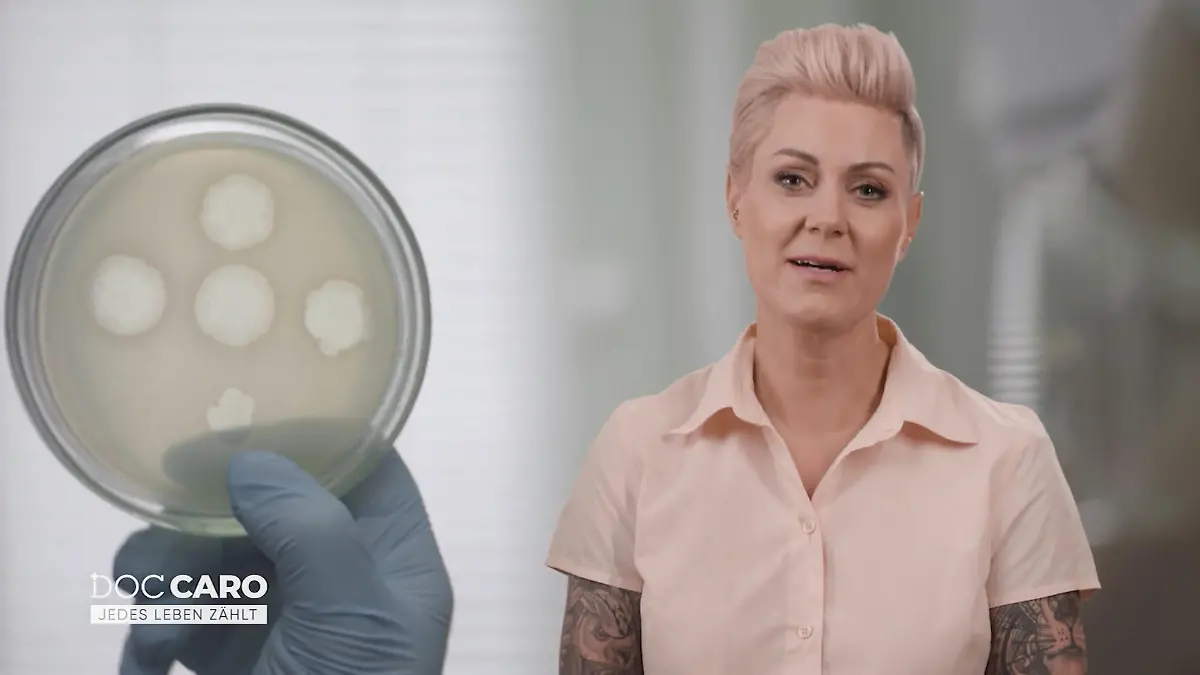
Die Phagentherapie könnte für viele eine Lösung sein Antibiotikaresistenz

Schule soll nicht geholfen haben„Untröstlich” – das sagen Mitschüler und deren Eltern nach Sarahs (9) tragischem Tod

Sie zerbrach wohl am Mobbing.
Am Samstag (11. Oktober) findet die Familie die kleine Sarah (9) zu Hause. Leblos. Sie soll Suizid begangen haben. In einem Abschiedsbrief sei zu lesen, dass sie schwere Hänseleien nicht mehr ertragen habe, berichten französische Medien. In ihrem Wohnort Sarreguemines trauern Tausende um das kleine Mädchen.
„Du bist fett, du bist hässlich, du bist eine Idiotin”
„Sie sagten ihr: ‘Du bist fett, du bist hässlich, du bist eine Idiotin’”, erzählt Louna, eine der besten Freundinnen von Sarah, dem Portal TF1 Info. „Sie sagte mir jeden Tag, dass sie die Nase voll habe und es nicht mehr ertragen könne.” Louna versuchte ihrer Freundin Mut zu machen und Beistand zu leisten. „Ich sagte ihr, es würde aufhören, aber es hörte nicht auf.” An der Schule sei eine Bande von sieben Mobbern aktiv.
Vor der Schule, in die das Mädchen ging, finden sich immer wieder Menschen ein. Mitschüler und ihre Eltern, Unbeteiligte, die das Kind nicht kannten, aber dessen Schicksal sie tief berührt. Yoann Simon, der rund 20 Kilometer entfernt lebt, kommt extra um eine weiße Rose als Zeichen der Trauer abzulegen. Yoann sagt dem Magazin Sudouest, dass er untröstlich sei. „Wir müssen etwas bewegen. Mobbing sollte bestraft werden“, schlägt er vor.
Lese-Tipp: Sarah (9) soll nach Mobbing in der Schule Suizid begangen haben
Elsa Deichel-Bohrer, Mutter zweier Kinder der betroffenen Schule, erklärt dem Sudouest, sie sei gekommen, um „die Familie des Mädchens“ zu unterstützen. Aber auch „die Schüler, weil sie wahrscheinlich nicht verstehen, was passiert ist“. Ihrer Meinung nach sollten wir „mehr als nur drei Stunden im Jahr mit ihnen über Mobbing sprechen“.
Dem Republicaine Lorraine sagt eine Mutter, die zwei von drei Kindern auf Sarahs Schule hat: „Wir sind untröstlich.”
Video-Tipp: Mobbing in der Schule! Zaids emotionale Geschichte
Rektor und Lehrer sollen nicht eingegriffen haben
„Wir hatten ein schreckliches Wochenende, wir können nicht schlafen“, erzählt eine Mutter dem Sudouest, die unbekannt bleiben will. „Ich habe ein Foto von ihrem Gesicht gesehen. Und seitdem versetze ich mich in die Lage ihrer Mutter. Wie soll sie mit diesem Schmerz leben?“, fragt sie sich. Und fügt hilflos hinzu: „Wenn unsere Kinder nach Hause kommen und uns erzählen, dass sie gemobbt werden, können wir ihnen sagen, dass sie es dem Lehrer sagen sollen, aber es ändert sich nichts.”
TF1 Info schreibt, dass Sarahs Mutter am Tag vor ihrem Suizid in der Schule gewesen sein soll, um das Mobbing zu melden. „Sie war ein Kind, das Hilfe suchte, aber letztendlich wurde ihr nicht zugehört“, so die Mutter eines Schülers. „Wir hatten denselben Schulleiter wie heute. Wir trauten uns nicht, über unsere Probleme zu sprechen. Die Lehrer lachten uns ins Gesicht. Der Schulleiter lachte uns ins Gesicht“, fügt Alyson, eine ehemalige Schülerin, hinzu.
Lese-Tipp: Schockierend: Jedes sechste Schulkind ist Opfer von Mobbing
Der neunjährige Abnor, ein Klassenkamerad Sarahs, berichtet, dass sie vor allem nach der Schule auf der Straße beleidigt worden sei. „Sie machten sich über sie lustig. Es ist nicht nett. Wir sind in einer Schule, um zu lernen, einen guten Job zu bekommen, Geld zu haben, es ist kein Ort für Mobbing. Nicht hier und nirgendwo sonst auf der Welt“, kommentiert das Kind.
Beratungsstelle an der Schule
Die Stadt Sarreguemines hat am Wochenende eine Beratungsstelle an der betroffenen Schule eingerichtet. Es soll Schülern und Schulpersonal „sofortige und angemessene” Unterstützung bieten, wie der Direktor des Nationalen Bildungsdienstes DASEN verspricht.
Lese-Tipp: Wie Detlef Soost dem Mobbing auf dem Schulhof entkam
Die weißen Rosen, die am Schultor hingen, sollen am Montagmorgen bereits entfernt worden sein. Ein Zettel teile mit: „Die Familie möchte nicht, dass ihr Blumen niederlegt.”
Hier findet ihr Hilfe in schwierigen Situationen
Solltet ihr selbst von Suizidgedanken betroffen sein, sucht euch bitte umgehend Hilfe. Versucht, mit anderen Menschen darüber zu sprechen! Das können Freunde oder Verwandte sein. Es gibt aber auch die Möglichkeit, anonym mit anderen Menschen über Ihre Gedanken zu sprechen. Das geht telefonisch, im Chat, per Mail oder persönlich.
Wenn ihr schnell Hilfe braucht, dann findet ihr unter der kostenlosen Telefon-Hotline 0800-1110111 oder 0800-1110222 Menschen, die euch Auswege aus schwierigen Situationen aufzeigen können.
Wenn du selbst schon negative Erfahrungen mit Mobbing in der Schule gemacht hast, ist es wichtig, darüber zu sprechen. Unter der Nummer 116 111 oder unter www.nummergegenkummer.de findest du Menschen, die dir zuhören.
Verwendete Quellen: Sudouest, TF1 Info, Républicaine Lorraine